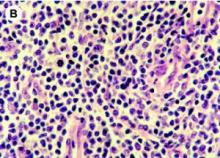

Vous recherchez une actualité
Actualités
Mode d'affichage :
-
ALZHEIMER: Peut-on attraper l'amyloïde pendant une chirurgie?
Actualité publiée il y a 10 années 2 moisAUTISME: Le gène en moins qui fait perdre 25 points de Q.I.
Actualité publiée il y a 10 années 2 mois
-
FIBROME UTÉRIN: L'embolisation, pour un retour à une qualité de vie, notamment sexuelle
Actualité publiée il y a 10 années 2 moisDÉVELOPPEMENT: La grande pauvreté appauvrit aussi les connexions du cerveau
Actualité publiée il y a 10 années 2 mois
-
ULCÈRE du PIED DIABÉTIQUE: L'oxygénothérapie ne réduit pas le risque d'amputation
Actualité publiée il y a 10 années 2 moisPARENTALITÉ: Petits enfants, petits problèmes, grands enfants, gros problèmes ?
Actualité publiée il y a 10 années 2 mois
-
CANCER COLORECTAL: 15% des diagnostics sont posés avant 50 ans
Actualité publiée il y a 10 années 2 moisCERVEAU: Une capacité d'un pétaoctet pour une consommation de 20 watts
Actualité publiée il y a 10 années 2 mois
-
PLAIES CHRONIQUES: Découverte d'un puissant facteur empêcheur de cicatrisation
Actualité publiée il y a 10 années 2 moisAUTISME: Des singes transgéniques autistes pour décrypter le processus neurophysiologique
Actualité publiée il y a 10 années 2 mois
-
MALADIE du SOMMEIL: Et si le parasite était asexué ?
Actualité publiée il y a 10 années 2 moisCANCER de la PEAU: Quand les bactéries prêtent main forte aux cellules cancéreuses
Actualité publiée il y a 10 années 2 mois
-
INCONTINENCE: 30% des femmes choisissent encore la fuite
Actualité publiée il y a 10 années 2 moisPSYCHO: Faire la part des choses, un signe de sensibilité ou à d'indécision?
Actualité publiée il y a 10 années 2 mois
-
SYNDROME de FATIGUE CHRONIQUE: Il n'épargne pas les enfants
Actualité publiée il y a 10 années 2 moisPRÉMATURITÉ: Une goutte de sang pour confirmer l'âge gestationnel de l'enfant
Actualité publiée il y a 10 années 2 mois
-
CANCER de l'OVAIRE: Un nouveau facteur génétique identifié
Actualité publiée il y a 10 années 2 moisDÉVELOPPEMENT: La mémoire des tout-petits prédit le risque de décrochage à 12 ans
Actualité publiée il y a 10 années 2 mois
-
SOIN des BRÛLURES: Le bio-printing ou de la peau imprimée en 3D
Actualité publiée il y a 10 années 2 moisMÉDECINE RÉGÉNÉRATIVE: Des micro-ARN qui ordonnent aux cellules de réparer l'os
Actualité publiée il y a 10 années 2 mois
-
PARKINSON: L'exercice physique reconnecte les neurones
Actualité publiée il y a 10 années 2 moisLe TROUBLE DÉPRESSIF saisonnier, un mythe ?
Actualité publiée il y a 10 années 2 mois
-
OBÉSITÉ: Un weekend de junk food suffit à bouleverser le microbiote
Actualité publiée il y a 10 années 2 moisDOULEUR CHRONIQUE: L'espoir d'amadouer nos capteurs de douleur
Actualité publiée il y a 10 années 2 mois
-
ATHÉROSCLÉROSE et maladie cardiaque: De l'ail contre la plaque
Actualité publiée il y a 10 années 2 moisVIRUS ZIKA et microcéphalies: Actualisation de la prise en charge des femmes enceintes
Actualité publiée il y a 10 années 2 mois
-
GROSSESSE: La dépression paternelle associée au risque de grande prématurité
Actualité publiée il y a 10 années 2 moisVIVRE avec une PLAIE: L'importance des facteurs psychologiques
Actualité publiée il y a 10 années 2 mois
-
OMEGA 3: Contre le déclin cognitif, alors efficaces ou pas?
Actualité publiée il y a 10 années 2 moisTIERS PAYANT: Généralisé au 30 novembre 2017
Actualité publiée il y a 10 années 2 mois
-
INFERTILITÉ: Aujourd'hui, pour rencontrer l'ovule, le spermatozoïde préfère être motorisé
Actualité publiée il y a 10 années 2 moisLYMPHOME associé au virus d'Epstein-Barr: Une nouvelle immunothérapie adoptive
Actualité publiée il y a 10 années 2 mois
-
ANXIÉTÉ: Comment le cerveau peut nous faire perdre tous nos moyens
Actualité publiée il y a 10 années 2 moisIMMUNITÉ: Trop d'acide folique affaiblit la réponse immunitaire
Actualité publiée il y a 10 années 2 mois
Pages